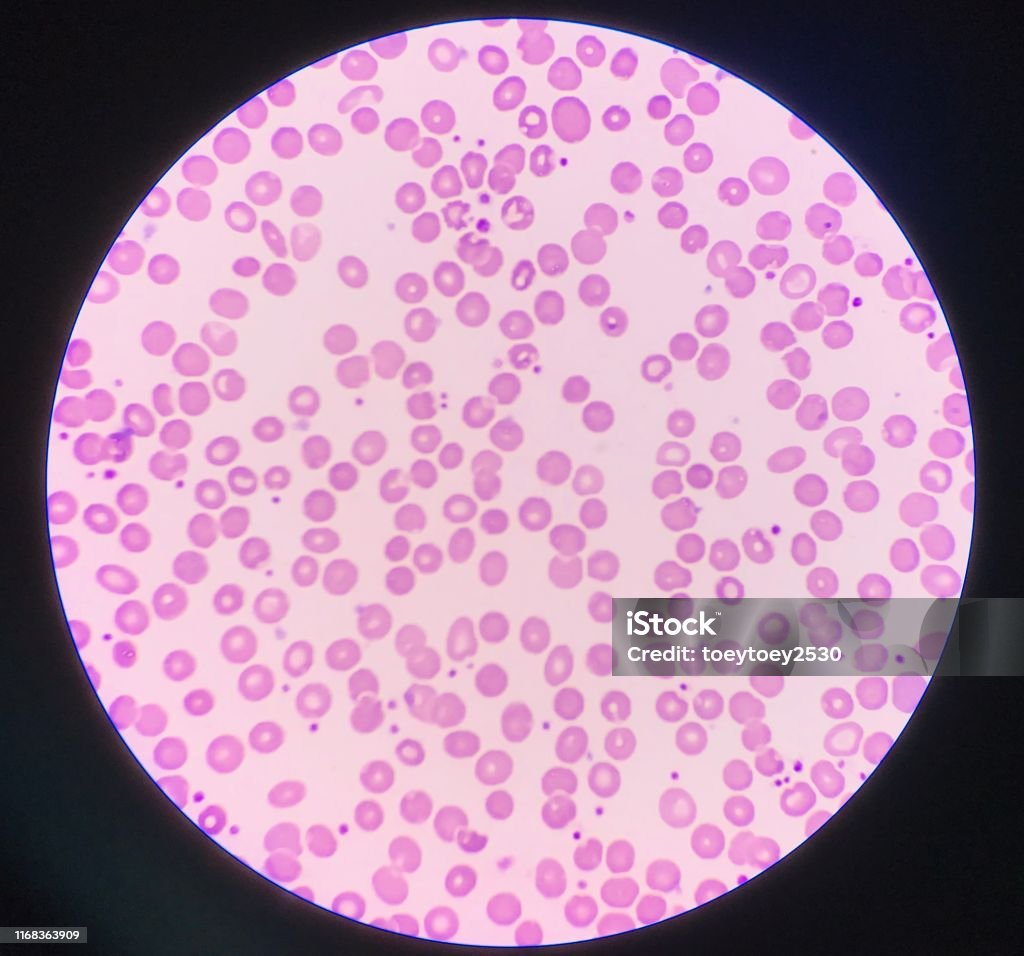

Chủ đề kính hiển vi 100x: Kính hiển vi camera là một thiết bị tiên tiến, kết hợp giữa công nghệ quang học và kỹ thuật số, mang lại sự đột phá trong nghiên cứu khoa học và ứng dụng thực tế. Bài viết này sẽ giới thiệu về các loại kính hiển vi camera phổ biến, ứng dụng của chúng, cũng như những lợi ích mà chúng mang lại cho nhiều lĩnh vực.
Mục lục
- Kính Hiển Vi Camera
- Tổng Quan Về Kính Hiển Vi Camera
- Phân Loại Kính Hiển Vi Camera
- Các Hãng Sản Xuất Kính Hiển Vi Camera Uy Tín
- Ứng Dụng Của Kính Hiển Vi Camera Trong Các Lĩnh Vực
- Cách Chọn Mua Kính Hiển Vi Camera Phù Hợp
- Lợi Ích Của Việc Sử Dụng Kính Hiển Vi Camera
- Xu Hướng Phát Triển Của Kính Hiển Vi Camera
Kính Hiển Vi Camera
Kính hiển vi camera là một thiết bị quan trọng trong nghiên cứu khoa học và giáo dục, được sử dụng rộng rãi trong các phòng thí nghiệm, cơ sở y tế, và cả trong lĩnh vực công nghiệp. Sự kết hợp giữa kính hiển vi truyền thống và camera kỹ thuật số giúp người dùng có thể quan sát, chụp ảnh và quay video các mẫu vật với độ chi tiết cao. Đây là công cụ lý tưởng để phân tích, nghiên cứu các mẫu vật có kích thước nhỏ mà mắt thường không thể nhìn thấy.
Ứng Dụng Của Kính Hiển Vi Camera
- Nghiên cứu khoa học: Kính hiển vi camera được sử dụng để nghiên cứu các tế bào, vi khuẩn, và các hiện tượng vi mô trong sinh học, y học, và các ngành khoa học khác.
- Giáo dục: Các trường học và đại học sử dụng kính hiển vi camera để giảng dạy và thực hành trong các khóa học về sinh học, hóa học, và vật lý.
- Công nghiệp: Trong ngành công nghiệp, kính hiển vi camera hỗ trợ trong việc kiểm tra chất lượng, phân tích bề mặt vật liệu, và nghiên cứu công nghệ mới.
Các Loại Kính Hiển Vi Camera Phổ Biến
Có nhiều loại kính hiển vi camera khác nhau tùy thuộc vào mục đích sử dụng. Dưới đây là một số loại phổ biến:
- Kính hiển vi camera sinh học: Được sử dụng rộng rãi trong các phòng thí nghiệm sinh học để nghiên cứu tế bào và mô.
- Kính hiển vi camera điện tử: Loại kính hiển vi này sử dụng tia điện tử thay vì ánh sáng để tạo ra hình ảnh chi tiết của mẫu vật.
- Kính hiển vi camera soi nổi: Phù hợp để quan sát các vật thể ba chiều với độ phóng đại thấp, thường được sử dụng trong công nghiệp và bảo trì.
Các Hãng Sản Xuất Kính Hiển Vi Camera Nổi Tiếng
Nhiều hãng sản xuất nổi tiếng trên thế giới cung cấp các loại kính hiển vi camera với chất lượng và độ bền cao. Một số hãng tiêu biểu bao gồm:
- Olympus: Cung cấp các sản phẩm kính hiển vi chất lượng cao, được sử dụng rộng rãi trong nghiên cứu và giáo dục.
- Zeiss: Nổi tiếng với các sản phẩm kính hiển vi có độ phân giải cao, đặc biệt là trong lĩnh vực y tế và khoa học đời sống.
- Nikon: Được biết đến với các sản phẩm kính hiển vi tiên tiến, hỗ trợ nghiên cứu trong nhiều lĩnh vực khác nhau.
Cách Chọn Mua Kính Hiển Vi Camera
Khi chọn mua kính hiển vi camera, người dùng cần xem xét các yếu tố như:
- Mục đích sử dụng: Chọn loại kính phù hợp với lĩnh vực nghiên cứu hoặc công việc cần thực hiện.
- Độ phóng đại: Xem xét khả năng phóng đại của kính hiển vi để đáp ứng nhu cầu quan sát chi tiết của mẫu vật.
- Chất lượng hình ảnh: Chọn các loại kính hiển vi có camera chất lượng cao để đảm bảo hình ảnh sắc nét và chính xác.
- Thương hiệu: Nên chọn các sản phẩm từ các hãng uy tín để đảm bảo chất lượng và dịch vụ hậu mãi tốt.
Kết Luận
Kính hiển vi camera là một thiết bị không thể thiếu trong nhiều lĩnh vực nghiên cứu và ứng dụng. Với sự phát triển của công nghệ, các loại kính hiển vi camera ngày càng trở nên đa dạng và tiên tiến hơn, đáp ứng tốt hơn nhu cầu của người dùng. Việc lựa chọn một sản phẩm phù hợp sẽ giúp bạn tối ưu hóa công việc nghiên cứu và giảng dạy, đồng thời tiết kiệm thời gian và chi phí.

.png)
Tổng Quan Về Kính Hiển Vi Camera
Kính hiển vi camera là sự kết hợp giữa kính hiển vi truyền thống và công nghệ camera kỹ thuật số, mang lại khả năng quan sát và phân tích hình ảnh mẫu vật với độ chi tiết cao. Thiết bị này đã trở thành một công cụ quan trọng trong nhiều lĩnh vực, từ nghiên cứu khoa học đến giáo dục và công nghiệp.
Kính hiển vi camera cho phép người dùng quan sát các mẫu vật với độ phóng đại lớn, đồng thời chụp ảnh hoặc quay video để lưu trữ và chia sẻ. Dưới đây là những đặc điểm nổi bật của kính hiển vi camera:
- Độ phân giải cao: Camera gắn trên kính hiển vi có độ phân giải cao, giúp ghi lại hình ảnh sắc nét của mẫu vật.
- Khả năng lưu trữ và chia sẻ: Hình ảnh và video từ kính hiển vi có thể được lưu trữ dưới dạng kỹ thuật số và dễ dàng chia sẻ qua các nền tảng khác nhau.
- Tích hợp phần mềm phân tích: Nhiều loại kính hiển vi camera đi kèm với phần mềm phân tích hình ảnh, giúp người dùng đo đạc và phân tích các thông số của mẫu vật.
Các loại kính hiển vi camera phổ biến trên thị trường hiện nay bao gồm:
- Kính hiển vi camera sinh học: Được sử dụng để nghiên cứu các mẫu sinh học như tế bào và mô.
- Kính hiển vi camera điện tử: Sử dụng tia điện tử để tạo ra hình ảnh chi tiết của mẫu vật.
- Kính hiển vi camera soi nổi: Dùng để quan sát các vật thể ba chiều với độ phóng đại thấp.
Kính hiển vi camera không chỉ nâng cao khả năng quan sát mà còn mang lại nhiều tiện ích trong việc lưu trữ và phân tích dữ liệu. Đây là công cụ lý tưởng cho các nhà nghiên cứu, giáo viên, và cả các chuyên gia trong ngành công nghiệp.
Phân Loại Kính Hiển Vi Camera
Kính hiển vi camera hiện đại được phân loại dựa trên nhiều yếu tố khác nhau, như mục đích sử dụng, công nghệ tích hợp và loại hình quan sát. Dưới đây là các phân loại phổ biến của kính hiển vi camera:
- Kính Hiển Vi Camera Sinh Học
Kính hiển vi camera sinh học được thiết kế để quan sát các mẫu sinh học như tế bào, vi khuẩn, và các mô sinh học. Loại kính này thường có độ phóng đại cao và được trang bị camera có độ phân giải lớn, giúp ghi lại hình ảnh chi tiết của mẫu vật để phục vụ cho nghiên cứu và giảng dạy.
- Kính Hiển Vi Camera Điện Tử
Loại kính hiển vi này sử dụng tia điện tử thay vì ánh sáng để quan sát mẫu vật. Kính hiển vi camera điện tử có khả năng phóng đại và độ phân giải rất cao, cho phép quan sát các cấu trúc ở cấp độ nguyên tử. Nó thường được sử dụng trong các nghiên cứu vật lý, hóa học và sinh học tiên tiến.
- Kính Hiển Vi Camera Soi Nổi
Kính hiển vi camera soi nổi, hay còn gọi là kính hiển vi lập thể, cho phép quan sát các vật thể ba chiều với độ phóng đại thấp. Loại kính này thường được sử dụng trong công nghiệp, bảo trì và sửa chữa các linh kiện điện tử, hoặc nghiên cứu côn trùng học. Hình ảnh thu được thường có chiều sâu và chi tiết bề mặt rõ ràng.
- Kính Hiển Vi Camera Cầm Tay
Kính hiển vi camera cầm tay là một thiết bị di động, cho phép người dùng quan sát mẫu vật một cách linh hoạt. Thiết bị này phù hợp cho các công việc cần di chuyển nhiều, như kiểm tra hiện trường, giáo dục di động, và nghiên cứu thực địa. Với trọng lượng nhẹ và khả năng kết nối trực tiếp với máy tính hoặc thiết bị di động, kính hiển vi cầm tay rất tiện lợi và dễ sử dụng.
- Kính Hiển Vi Camera Kỹ Thuật Số
Kính hiển vi camera kỹ thuật số tích hợp sẵn camera kỹ thuật số, cho phép chụp ảnh và quay video trực tiếp từ kính hiển vi. Các loại kính này thường đi kèm với phần mềm xử lý hình ảnh, giúp phân tích và lưu trữ dữ liệu một cách hiệu quả. Kính hiển vi kỹ thuật số là lựa chọn lý tưởng cho các nhà nghiên cứu cần chia sẻ dữ liệu trực tuyến hoặc thực hiện các bài giảng trực tuyến.
Việc lựa chọn loại kính hiển vi camera phù hợp phụ thuộc vào mục đích sử dụng và yêu cầu kỹ thuật của người dùng. Mỗi loại kính hiển vi đều có những ưu điểm riêng, hỗ trợ tối đa cho công việc quan sát và nghiên cứu trong nhiều lĩnh vực khác nhau.

Các Hãng Sản Xuất Kính Hiển Vi Camera Uy Tín
Trên thị trường hiện nay, có nhiều hãng sản xuất kính hiển vi camera uy tín, nổi tiếng với chất lượng và công nghệ tiên tiến. Dưới đây là một số hãng sản xuất hàng đầu mà người dùng có thể tin tưởng lựa chọn:
- Olympus
Olympus là một trong những hãng sản xuất thiết bị quang học hàng đầu thế giới, nổi tiếng với các dòng kính hiển vi camera chất lượng cao. Sản phẩm của Olympus thường được sử dụng trong nghiên cứu khoa học, y tế và giáo dục, nhờ vào độ chính xác và độ bền vượt trội.
- Zeiss
Zeiss là thương hiệu Đức nổi tiếng với công nghệ quang học tiên tiến, đặc biệt trong lĩnh vực kính hiển vi. Kính hiển vi camera của Zeiss được đánh giá cao về độ phân giải và khả năng tái tạo hình ảnh chi tiết, làm hài lòng cả những người dùng chuyên nghiệp nhất.
- Nikon
Nikon không chỉ nổi tiếng với các sản phẩm máy ảnh mà còn với các thiết bị kính hiển vi camera. Nikon cung cấp các dòng sản phẩm đa dạng, từ kính hiển vi sinh học đến kính hiển vi điện tử, phục vụ cho nhiều lĩnh vực nghiên cứu và ứng dụng khác nhau.
- Leica
Leica là một tên tuổi lớn trong ngành công nghiệp quang học, đặc biệt nổi bật với các sản phẩm kính hiển vi camera. Các sản phẩm của Leica được biết đến với thiết kế tinh tế và chất lượng quang học tuyệt vời, phù hợp cho cả nghiên cứu và giáo dục.
- Euromex
Euromex là một thương hiệu châu Âu chuyên cung cấp các loại kính hiển vi camera với mức giá phải chăng nhưng vẫn đảm bảo chất lượng. Euromex là lựa chọn phù hợp cho các phòng thí nghiệm và trường học với ngân sách hạn chế nhưng yêu cầu cao về hiệu suất.
- Terino
Terino là một trong những hãng sản xuất kính hiển vi camera đáng chú ý với các sản phẩm tập trung vào công nghệ kỹ thuật số và phần mềm phân tích. Terino cung cấp các giải pháp toàn diện cho việc lưu trữ, phân tích và chia sẻ hình ảnh mẫu vật, đáp ứng nhu cầu của các nhà nghiên cứu hiện đại.
Khi chọn mua kính hiển vi camera, việc lựa chọn hãng sản xuất uy tín là rất quan trọng để đảm bảo chất lượng sản phẩm và dịch vụ hậu mãi. Các thương hiệu trên đều đã khẳng định được vị thế của mình trên thị trường toàn cầu, cung cấp những sản phẩm đáng tin cậy cho người dùng.
Ứng Dụng Của Kính Hiển Vi Camera Trong Các Lĩnh Vực
Kính hiển vi camera đã trở thành một công cụ thiết yếu trong nhiều lĩnh vực, nhờ khả năng kết hợp giữa quan sát trực tiếp và ghi lại hình ảnh chất lượng cao. Dưới đây là những ứng dụng nổi bật của kính hiển vi camera trong các lĩnh vực khác nhau:
- Nghiên Cứu Khoa Học
Trong nghiên cứu khoa học, kính hiển vi camera giúp các nhà khoa học quan sát chi tiết các mẫu vật ở cấp độ vi mô. Thiết bị này được sử dụng rộng rãi trong các thí nghiệm về sinh học, hóa học, vật lý và vật liệu học, cho phép ghi lại và phân tích các hiện tượng một cách chính xác và dễ dàng.
- Y Tế Và Chẩn Đoán
Kính hiển vi camera đóng vai trò quan trọng trong lĩnh vực y tế, đặc biệt là trong việc chẩn đoán các bệnh lý. Bác sĩ có thể sử dụng thiết bị này để quan sát các mẫu sinh học, như mô, tế bào, hoặc mẫu máu, từ đó phát hiện các dấu hiệu bệnh lý và đưa ra phương pháp điều trị hiệu quả.
- Giáo Dục Và Đào Tạo
Kính hiển vi camera là công cụ hỗ trợ đắc lực trong giảng dạy và đào tạo. Giáo viên có thể sử dụng thiết bị này để minh họa trực quan cho học sinh, sinh viên về các khái niệm vi mô, từ đó giúp họ hiểu rõ hơn về cấu trúc và chức năng của các sinh vật cũng như vật chất.
- Công Nghiệp Và Sản Xuất
Trong lĩnh vực công nghiệp, kính hiển vi camera được sử dụng để kiểm tra chất lượng sản phẩm và phân tích các khiếm khuyết trong quá trình sản xuất. Thiết bị này hỗ trợ các kỹ sư và chuyên gia kỹ thuật trong việc kiểm tra các linh kiện nhỏ, vi mạch, và các sản phẩm công nghệ cao khác.
- Kiểm Tra Hiện Trường Và Phân Tích Pháp Y
Kính hiển vi camera cũng được ứng dụng trong các hoạt động kiểm tra hiện trường và phân tích pháp y. Thiết bị này giúp các chuyên gia phát hiện và phân tích các bằng chứng nhỏ như sợi vải, dấu vân tay, hoặc mảnh vụn tại hiện trường, từ đó hỗ trợ điều tra các vụ án hình sự.
Nhờ vào tính linh hoạt và khả năng cung cấp dữ liệu hình ảnh chi tiết, kính hiển vi camera ngày càng trở nên phổ biến và quan trọng trong nhiều lĩnh vực khác nhau, từ khoa học cơ bản đến ứng dụng công nghiệp và y tế.

Cách Chọn Mua Kính Hiển Vi Camera Phù Hợp
Việc chọn mua kính hiển vi camera phù hợp đòi hỏi người dùng phải cân nhắc nhiều yếu tố khác nhau, từ nhu cầu sử dụng đến ngân sách. Dưới đây là hướng dẫn chi tiết giúp bạn chọn lựa sản phẩm phù hợp nhất:
- Xác Định Mục Đích Sử Dụng
Trước tiên, bạn cần xác định rõ mục đích sử dụng kính hiển vi camera. Nếu bạn cần sử dụng trong nghiên cứu khoa học, thì các dòng kính có độ phân giải cao và khả năng phóng đại lớn sẽ là lựa chọn tốt. Ngược lại, nếu chỉ sử dụng cho giáo dục hoặc công việc thường ngày, bạn có thể chọn các dòng kính hiển vi cơ bản với giá thành hợp lý hơn.
- Kiểm Tra Độ Phóng Đại
Độ phóng đại là yếu tố quan trọng trong việc chọn kính hiển vi camera. Bạn cần chọn sản phẩm có độ phóng đại phù hợp với nhu cầu quan sát của mình. Ví dụ, để quan sát tế bào hoặc vi khuẩn, kính hiển vi với độ phóng đại từ 400x đến 1000x là lý tưởng.
- Độ Phân Giải Của Camera
Độ phân giải của camera tích hợp là yếu tố quyết định đến chất lượng hình ảnh thu được. Độ phân giải càng cao, hình ảnh càng sắc nét và chi tiết. Bạn nên chọn camera có độ phân giải tối thiểu 2 MP cho nhu cầu cơ bản và cao hơn nếu cần chất lượng hình ảnh tốt hơn.
- Khả Năng Kết Nối Và Tương Thích
Kính hiển vi camera hiện đại thường đi kèm với nhiều cổng kết nối như USB, HDMI hoặc Wi-Fi. Điều này giúp bạn dễ dàng kết nối kính hiển vi với máy tính, TV hoặc các thiết bị di động để hiển thị và lưu trữ hình ảnh. Hãy đảm bảo rằng sản phẩm bạn chọn có khả năng tương thích với các thiết bị bạn đang sử dụng.
- Chọn Thương Hiệu Uy Tín
Chất lượng sản phẩm phụ thuộc nhiều vào thương hiệu sản xuất. Các hãng nổi tiếng như Olympus, Nikon, Zeiss, Leica, và Euromex đều cung cấp các sản phẩm kính hiển vi camera chất lượng cao. Bạn nên chọn mua từ các thương hiệu này để đảm bảo sản phẩm bền bỉ và có chế độ bảo hành tốt.
- Xem Xét Ngân Sách
Cuối cùng, hãy xem xét ngân sách của bạn. Giá cả của kính hiển vi camera có thể dao động rất lớn, từ vài triệu đến hàng chục triệu đồng. Bạn cần cân nhắc giữa các tính năng cần thiết và ngân sách của mình để chọn được sản phẩm phù hợp nhất.
Bằng cách làm theo các bước trên, bạn sẽ dễ dàng chọn được một chiếc kính hiển vi camera phù hợp với nhu cầu và ngân sách của mình, giúp nâng cao hiệu quả công việc và nghiên cứu.
XEM THÊM:
Lợi Ích Của Việc Sử Dụng Kính Hiển Vi Camera
Việc sử dụng kính hiển vi camera mang lại nhiều lợi ích vượt trội, giúp cải thiện quá trình quan sát và phân tích hình ảnh. Dưới đây là những lợi ích nổi bật:
Tăng Cường Khả Năng Quan Sát
- Phóng Đại Chi Tiết: Kính hiển vi camera giúp phóng đại các chi tiết nhỏ, cho phép người dùng quan sát rõ ràng hơn các đối tượng mà mắt thường không thể thấy.
- Hình Ảnh Sắc Nét: Các camera hiện đại đi kèm với kính hiển vi có khả năng cung cấp hình ảnh độ phân giải cao, giúp người dùng nhìn thấy rõ ràng và chính xác hơn.
Lưu Trữ Và Chia Sẻ Dữ Liệu Dễ Dàng
- Lưu Trữ Dữ Liệu: Hình ảnh và video được chụp bởi kính hiển vi camera có thể dễ dàng lưu trữ trên các thiết bị điện tử như máy tính, giúp việc lưu giữ và quản lý dữ liệu trở nên thuận tiện hơn.
- Chia Sẻ Nhanh Chóng: Người dùng có thể chia sẻ hình ảnh và video qua các nền tảng số một cách nhanh chóng, phục vụ cho mục đích học tập, nghiên cứu và chẩn đoán từ xa.
Tiết Kiệm Thời Gian Và Chi Phí
- Tối Ưu Hóa Quy Trình: Với khả năng ghi lại và phân tích hình ảnh tức thì, kính hiển vi camera giúp giảm thời gian cần thiết cho việc quan sát và ghi chú thủ công.
- Chi Phí Hiệu Quả: Mặc dù đầu tư ban đầu có thể cao, nhưng việc sử dụng kính hiển vi camera giúp giảm chi phí dài hạn nhờ khả năng tái sử dụng và chia sẻ tài liệu mà không cần in ấn hoặc sao chép thủ công.

Xu Hướng Phát Triển Của Kính Hiển Vi Camera
Trong những năm gần đây, công nghệ kính hiển vi camera đã chứng kiến nhiều bước tiến quan trọng, mở ra những xu hướng phát triển mới, đáp ứng nhu cầu ngày càng cao của người sử dụng. Các xu hướng này không chỉ tập trung vào việc nâng cao chất lượng hình ảnh mà còn tích hợp nhiều tính năng hiện đại, tạo sự thuận tiện và hiệu quả cao trong công việc nghiên cứu và ứng dụng.
1. Tích Hợp Công Nghệ 4K và Cao Hơn
Xu hướng đầu tiên và nổi bật nhất là sự tích hợp của công nghệ 4K trong các kính hiển vi camera, cho phép quan sát các mẫu vật với độ phân giải cực kỳ cao. Công nghệ này không chỉ mang đến hình ảnh sắc nét, chi tiết hơn mà còn giúp người dùng dễ dàng phóng to và quan sát các cấu trúc nhỏ mà không bị mất chi tiết. Trong tương lai, chúng ta có thể mong đợi các kính hiển vi camera với độ phân giải còn cao hơn, chẳng hạn như 8K.
2. Kết Nối Không Dây và Tích Hợp IoT
Một xu hướng khác là sự phát triển của các kính hiển vi camera với khả năng kết nối không dây, cho phép truyền dữ liệu trực tiếp đến các thiết bị khác mà không cần dây cáp. Điều này mang lại sự linh hoạt trong việc sử dụng và chia sẻ thông tin. Hơn nữa, tích hợp Internet of Things (IoT) đang dần trở thành một tiêu chuẩn mới, giúp các thiết bị kính hiển vi có thể kết nối và hoạt động đồng bộ trong hệ thống nghiên cứu khoa học và công nghiệp.
3. Ứng Dụng Trí Tuệ Nhân Tạo (AI)
Trí tuệ nhân tạo (AI) đang được áp dụng rộng rãi trong nhiều lĩnh vực, và kính hiển vi camera cũng không ngoại lệ. AI có khả năng hỗ trợ việc phân tích hình ảnh tự động, giúp nhận diện và phân loại các cấu trúc trong mẫu vật nhanh chóng và chính xác hơn. Điều này không chỉ giảm tải công việc cho người sử dụng mà còn tăng độ tin cậy và chính xác trong các nghiên cứu khoa học.
4. Sự Phổ Biến Của Kính Hiển Vi Camera Cầm Tay
Kính hiển vi camera cầm tay đang trở thành lựa chọn phổ biến nhờ tính linh hoạt và tiện lợi của chúng. Những thiết bị này thường có kích thước nhỏ gọn, dễ dàng mang theo và sử dụng trong nhiều hoàn cảnh khác nhau, từ nghiên cứu hiện trường đến các ứng dụng trong giáo dục và công nghiệp.
5. Nâng Cao Khả Năng Lưu Trữ và Chia Sẻ Dữ Liệu
Cuối cùng, khả năng lưu trữ và chia sẻ dữ liệu của kính hiển vi camera cũng được cải thiện rõ rệt. Các hệ thống mới không chỉ cho phép lưu trữ lượng lớn hình ảnh và video với chất lượng cao mà còn hỗ trợ các tính năng chia sẻ qua mạng xã hội, email, hoặc các dịch vụ đám mây, giúp công việc nghiên cứu và giảng dạy trở nên dễ dàng và hiệu quả hơn.
Những xu hướng này cho thấy tương lai tươi sáng và đầy tiềm năng của kính hiển vi camera, hứa hẹn mang lại nhiều đột phá mới trong khoa học và công nghệ.
